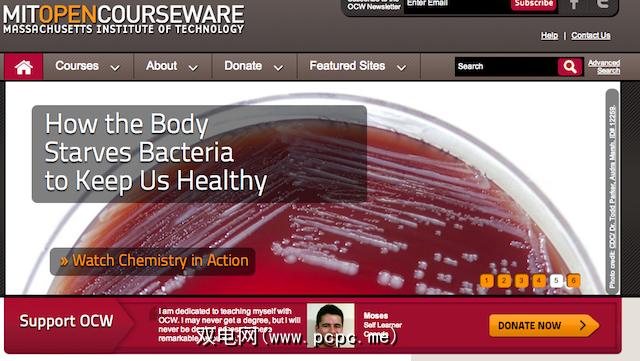

如果您对在线免费教育感兴趣,您可能已经听说过一些著名的名字:Coursera,Khan Academy,MIT等。但是现在这些学习途径已经司空见惯,在它们之间进行选择也有些噩梦。并决定使用哪种学习系统。
提供免费在线教育的顶级大学
许多大学现在都公开提供其讲座的访问权限,因为这是展示其课程和课程的好方法大方。麻省理工学院,斯坦福大学,哈佛大学,耶鲁大学,卡内基·梅隆大学,加州大学洛杉矶分校和伯克利大学都在线提供了很多精彩的内容。但是,由于与MOOC(大规模开放在线课程)网站建立了许多良好的合作关系,直接与大学学习这些讲座并不总是明智的。
您可以看到,有很多提供免费在线教育的一流大学。诀窍不仅是找到一所提供丰富内容的大学,甚至是找到正确的信息,还在于找到适合您的学习方法。
报名参加课程
许多人喜欢以更传统的方式注册课程,有时其目的是获得证书。该选项还使您可以轻松学习,因为您有一个转到的学习空间,提醒截止日期和学习时间的框架。对于那些不愿再继续在线学习的人来说,及时性是一个很大的吸引力。
库塞拉是教育界最著名的人之一。我们之前已经详细介绍了Coursera,但它们绝不是唯一提供此服务的站点。
澳大利亚站点Open2Study为世界各地的任何人提供免费课程,并提供大量主题。您可以按照自己的进度学习内容,并且可以选择在给定的时间范围内完成评估以获得证书。 Open2Study在各种尺寸的浏览器上都能很好地工作,因此您可以移动。该网站提供了澳大利亚顶尖大学的内容,使任何人都可以访问这些大学。这些课程大部分都是每周四小时,每周两小时。在撰写本文时,我认为这些大学中没有任何一家可以通过其他途径提供免费课程。

FutureLearn是一家新兴公司,提供各种国际大学(主要是英国)的免费课程。他们提供了一些真正独特的课程,并设计了供您在任何智能手机或浏览器上使用的网站。这些课程大多数都希望您在6-8周内每周投入2-3个小时。
iVersity在MOOC领域是一个真正的新参与者,刚刚在欧洲爆发。该课程提供了一个有趣的选择,每个人都有一些东西。同样有趣的是,它开设了德语课程,可能还会提供更多欧洲语言。这意味着对于想要在欧洲学习的欧洲人来说,这将迅速成为一个重大新闻,但是如果您想学习欧洲语言,这也可能是巩固您的语言学习的一种好方法。
也请查看
有数十个站点提供您正在寻找工作的课程经验和潜在证书。查看Udacity,Edx等。


带薪学位
如果您渴望获得学位,并且愿意花一点钱,请访问开放大学和开放大学。澳大利亚大学。如果您愿意为短期专业课程付费,那么Udemy之类的东西可能更适合您。

随意浏览和学习精彩内容
如果您不想签名要获得免费的大学课程,仍然有很多很棒的方法可以随便观看或收听讲座。
我们以前在关于如何免费获得大学水平教育的文章中介绍了汗学院。的确,这是一个着名的网站,提供许多很棒的课程。他们还使浏览新知识成为一种愉快的体验。通过Khan Academy,您可以浏览直到找到想要观看的特定讲座,然后就可以立即学习。他们还提供了一个出色的移动应用程序,使您随时随地都可以轻松学习。
尽管许多站点都与顶尖大学合作,提供了一种免费的学习方法,但该站点的功能却有所不同。 Academic Earth提供了课程的视频讲座列表,并使其易于访问。他们还提供了一个有趣的播放列表功能,策展人围绕这个有趣的主题,整理了许多不同课程的演讲。使用移动浏览器导航非常容易,因此您可以在旅途中或忙于其他任务时学习。


iTunes University最初是通过iTunes访问的播客的集合。由于将内容添加到iTunes播客目录非常容易,因此许多一流的大学和学校都这样做了,这使它成为了以音频或视频内容形式提供的大量有趣的演讲集。仍然可以通过iTunes商店浏览iTunesU,并且有大量令人难以置信的丰富内容可供学习。但是,Apple还提供iTunesU作为应用程序,这意味着它不仅比以往任何时候都更具访问性,而且还有可能找到提供阅读材料和作业的更丰富的课程。实际上,他们正在积极地推广iTunesU,以便全世界的教育工作者为他们的课堂提供课程材料,从而改善可用的授课内容。

上面的列表仅会让您入门。有很多其他方法可以找到免费的教育讲座以供学习,例如TED,HowStuffWorks,BrightTalk,Reddit大学等。不要限制自己!

教育搜索引擎
也有许多网站只是收集有关免费教育的信息,从而使您可以轻松地搜索要学习的新主题,例如OEdb,OpenCulture,Open Courseware联盟等。如果您想查找有关特定主题的讲座,这是进行搜索的最佳方法。

最适合您的是什么?
如您所见,直接前往单所大学通常不是进行在线学习的最佳方法。是否搜索特定内容,使用特定的生态系统或应用程序,还是决定注册课程,完全取决于您的判断。但是,它的确可以让您轻松找到一个或两个最喜欢的去教育地点以满足您的教育需求。
标签:
